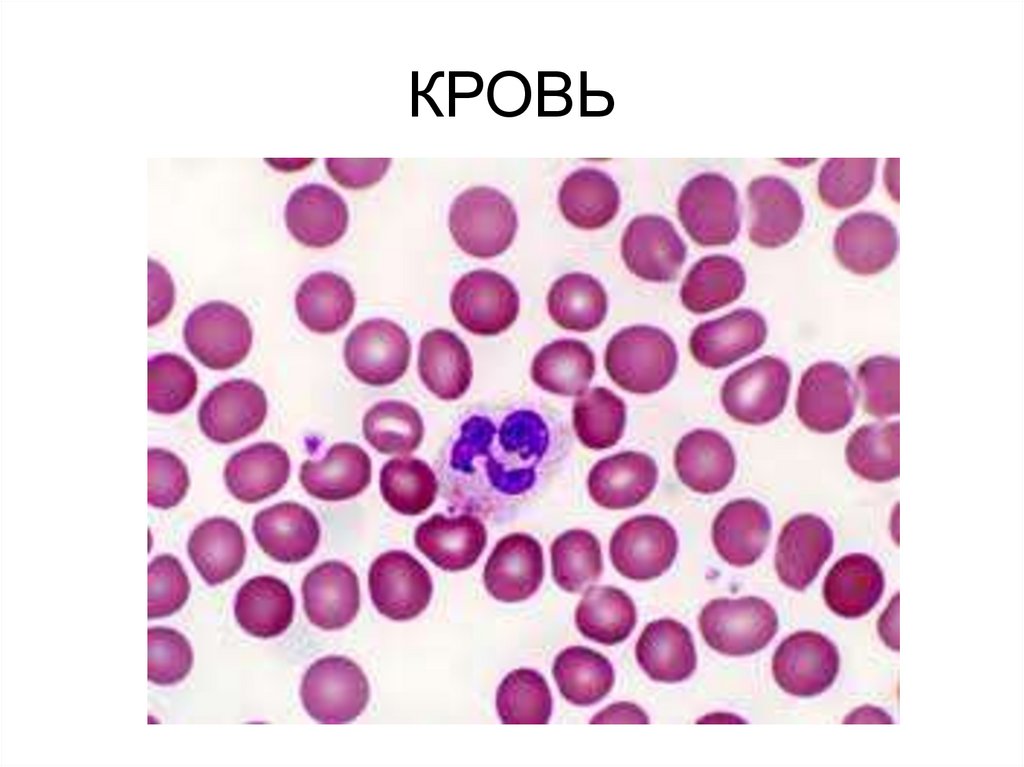
КРОВЬ

Похожие презентации:
Ткани
1. ТКАНЬ = клетки + межклеточное вещество
Сходное строение
Сходное происхождение
Общее местоположение
Общие функции
2. ТКАНИ человека и животных
• ЭПИТЕЛИАЛЬНЫЕ• СОЕДИНИТЕЛЬНЫЕ
• МЫШЕЧНЫЕ
• НЕРВНАЯ
3.
4. ПЛОСКИЙ ОДНОСЛОЙНЫЙ ЭПИТЕЛИЙ
ВЫСТИЛКА АЛЬВЕОЛ
СТЕНКИ КАПИЛЛЯРОВ
ВЫСТИЛКА АРТЕРИЙ И ВЕН
ВЫСТИЛКА КАМЕР СЕРДЦА
5. КУБИЧЕСКИЙ ЭПИТЕЛИЙ
• В ПОЧКАХ6. МЕРЦАТЕЛЬНЫЙ ЭПИТЕЛИЙ (многорядный призматический)
• ДЫХАТЕЛЬНЫЕ ПУТИ7.
8.
• СЛИЗИСТАЯОБОЛОЧКА ЩЁК;
• ПИЩЕВОД;
• ПРОТОКИ
СЛЮННЫХ И
МЛЕЧНЫХ ЖЕЛЕЗ
9.
10. ЖЕЛЕЗИСТЫЙ ЭПИТЕЛИЙ А. ЭКЗОКРИННЫЕ ЖЕЛЕЗЫ
• МЕРОКРИНОВАЯСЕКРЕЦИЯ ЧЕРЕЗ
МЕМБРАНЫ КЛЕТОК
/ПОТОВЫЕ/;
• АПОКРИНОВАЯ
СЕКРЕЦИЯ С ЧАСТЬЮ
ЦИТОПЛАЗМЫ
(МЛЕЧНЫЕ);
• ГОЛОКРИНОВАЯ
СЕКРЕЦИЯ
ВСЛЕДСТВИЕ
РАЗРЫВА КЛЕТКИ
(САЛЬНЫЕ).
11. ЖЕЛЕЗИСТЫЙ ЭПИТЕЛИЙ Б. ЭНДОКРИННЫЕ ЖЕЛЕЗЫ
• ЭПИФИЗ;• ГИПОФИЗ;
• ЩИТОВИДНАЯ
ЖЕЛЕЗА;
• ТИМУС;
• НАДПОЧЕЧНИКИ;
• ПОДЖЕЛУДОЧНАЯ
ЖЕЛЕЗА;
• ПОЛОВЫЕ
ЖЕЛЕЗЫ.
12. СОЕДИНИТЕЛЬНЫЕ ТКАНИ
ОСОБЕННОСТИ:1. ОТЛИЧНО РАЗВИТО МЕЖКЛЕТОЧНОЕ ВЕЩЕСТВО
2. НИЗКАЯ МЕТАБОЛИЧЕСКАЯ АКТИВНОСТЬ
13. СОБСТВЕННО СОЕДИНИТЕЛЬНЫЕ ТКАНИ
I.СОБСТВЕННО
СОЕДИНИТЕЛЬНЫЕ
ТКАНИ
14. РЫХЛАЯ ВОЛОКНИСТАЯ СОЕДИНИТЕЛЬНАЯ ТКАНЬ
15. РЫХЛАЯ ВОЛОКНИСТАЯ СОЕДИНИТЕЛЬНАЯ ТКАНЬ
16.
СклераНадкостница
Надхрящница
Клапаны сердца
Перикард
Твердая оболочка
мозга
В дерме кожи
Сухожилия
Связки
Фасции
17. II. ТКАНИ СО СПЕЦИАЛЬНЫМИ СВОЙСТВАМИ
18. ЖИРОВАЯ ТКАНЬ
19.
КРАСНЫЙ КОСТНЫЙ МОЗГОкраска гематоксилинэозином
1 - паренхима костного мозга
(кроветворные клетки)
2 - костные перекладины
4 - мегакариоцит
5 - кровеносные сосуды
20. III. ТВЁРДЫЕ СКЕЛЕТНЫЕ ТКАНИ
21. ХРЯЩЕВАЯ ТКАНЬ
22. КОСТНАЯ ТКАНЬ
23. IV. ЖИДКИЕ СОЕДИНИТЕЛЬНЫЕ ТКАНИ
24. ЛИМФОИДНАЯ ТКАНЬ
ТКАНЬ МИНДАЛИНЫТКАНЬ ЛИМФОУЗЛА
25. КРОВЬ
26. МЫШЕЧНЫЕ ТКАНИ
СВОЙСТВА:•ВОЗБУДИМОСТЬ;
•СОКРАТИМОСТЬ.
27. 1.ПОПЕРЕЧНОПОЛОСАТАЯ СКЕЛЕТНАЯ
• ПРОИЗВОЛЬНЫЕ;• ВЫСОКОСПЕЦИАЛИЗИРОВАННЫЕ;
• КЛЕТКИ=ВОЛОКНА ИЗ
САРКОМЕРОВ;
• КЛЕТКИ
МНОГОЯДЕРНЫЕ, С
ПОПЕРЕЧНОЙ
ИСЧЕРЧЕННОСТЬЮ;
• БЫСТРО
СОКРАЩАЮТСЯ И
БЫСТРО
УТОМЛЯЮТСЯ.
28. 2.ГЛАДКАЯ МЫШЕЧНАЯ
• НЕПРОИЗВОЛЬНЫЕ;• МЕНЕЕ
СПЕЦИАЛИЗИРОВАН-НЫЕ;
• КОРОТКИЕ
ВЕРЕТЕНОВИДНЫЕ
КЛЕТКИ В ПУЧКАХ;
• КЛЕТКИ 1-ЯДЕРНЫЕ,
БЕЗ ПОПЕРЕЧНОЙ
ИСЧЕРЧЕННОСТИ;
• МЕДЛЕННО
СОКРАЩАЮТСЯ И
РАССЛАБЛЯЮТСЯ.
29. 3.СЕРДЕЧНАЯ
• КЛЕТКИРАЗВЕТВЛЯЮТСЯ НА
КОНЦАХ И
СОЕДИНЯЮТСЯ ДРУГ С
ДРУГОМ;
• В КЛЕТКЕ НЕСКОЛЬКО
ЯДЕР, ЕСТЬ
ПОПЕРЕЧНАЯ
ИСЧЕРЧЕННОСТЬ;
• БЫСТРЫЕ СОКРАЩЕНИЯ
И РАССЛАБЛЕНИЯ БЕЗ
УТОМЛЕНИЯ;
• АВТОМАТИЯ.
30. НЕРВНАЯ ТКАНЬ = нейроны + нейроглия
31.
32. СТРОЕНИЕ НЕЙРОНА
33. ВИДЫ НЕЙРОНОВ
34. ВИДЫ НЕЙРОНОВ
НЕЙРОНЫ ПОФУНКЦИЯМ
ЧУВСТВИТЕЛЬНЫЕ
(сенсорные,
афферентные,
центростремительные)
ВСТАВОЧНЫЕ
(контактные,
промежуточные)
ИСПОЛНИТЕЛЬНЫЕ
(ДВИГАТЕЛЬНЫЕ =
моторные или
СЕКРЕТОРНЫЕ)
эфферентные
центробежные
35. СИНАПС – контакт нейрона с другой возбудимой клеткой
36. НЕРВНОЕ ВОЛОКНО – аксон, покрытый миелиновой оболочкой НЕРВ – пучок нервных волокон, окруженных соединительной тканью
(эпиневрием); может бытьчувствительным, двигательным,
смешанным
НЕРВНЫЙ УЗЕЛ – скопление тел
нейронов за пределами ЦНС
ЯДРО – скопление тел нейронов в
белом веществе ЦНС

Биология
Биология








